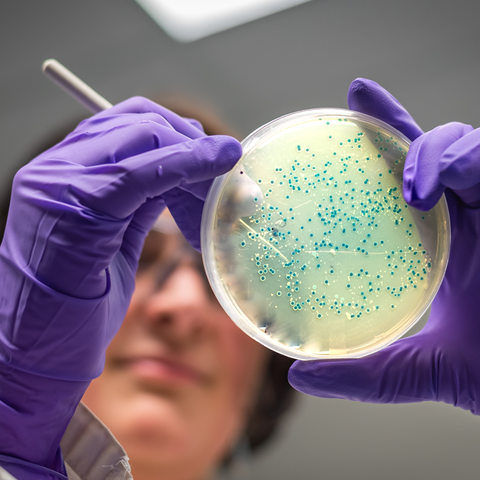

Comunicações e publicações relacionadas com a dieta cetogénica.
Notícias e receitas para viver a sua dieta.
Revista Dietflash

Na Dietflash estamos comprometidos com o seu bem-estar e saúde, por isso queremos partilhar consigo...

O jejum intermitente envolve alternar o jejum com períodos de alimentação. Existem vários tipos de...
O intestino delgado é responsável pela maior parte da digestão e absorção dos nutrientes encontrados...